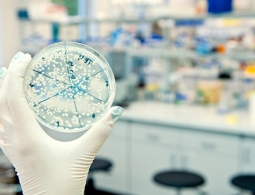
Ученые: антибиотики-"домушники" помогут победить супербактерий

Российские ученые помогли повысить эффективность лазерных систем
МОСКВА, 7 фев — РИА Новости. Международный коллектив ученых из России, Греции и Казахстана сделал открытие, важное для повышения эффективности работы лазерных систем, применяемых, в том числе в медицине, результаты работы опубликованы в издании Scie...
Который час? Пять лучших теорий на тему четвертого измерения
«Время — это то, что мешает тому, чтобы все происходило одновременно». Заявление физика Джона Уилера справедливо резюмирует то, что делает время, в отличие от чего-либо другого. Особенно это выделяется на фоне того, что наша охота на самые базовые ингредиенты реальности не принесла...
Китай стал крупнейшим производителем солнечной энергии в мире
В чём китайцы хороши, так это в утирании носа другим государствам в таких областях, как промышленность, строительство или даже высокие технологии вроде генетики. Вот и на этот раз Китай вновь доказал, что способен на многое, став крупнейшим в мире производителем солнечной энергии. Достижение эт...
СМИ: в РАН считают гомеопатию лженаукой
МОСКВА, 6 фев — РИА Новости. Комиссия по борьбе с лженаукой при президиуме Российской академии наук (РАН) советует Минздраву РФ изъять гомеопатические лекарства из государственных клиник, пишет в понедельник газета "Коммерсант".Комиссия подготов...
Физик: гелий поможет России стать лидером в производстве нанопроводов
МОСКВА, 5 фев – РИА Новости. Профессор Евгений Гордон из Института проблем химической физики РАН в Черноголовке рассказал об уникальной методике производства сверхчистых и сверхтонких нанопроводов в жидком гелии, созданной в его лаборатории, и объяснил,...
В Китае сделали микроволновую пушку, которая может сбивать ракеты и выводить из строя танки
Как сообщает редакция издания Popular Science, группа китайских ученых из Северо-западного института ядерных технологий создала рабочий образец микроволновой пушки, способной на расстоянии выводить из строя различную технику. От всех прочих образцов подобного оружия это изобретение отличается в перв...
СМИ: исследователи назвали три вероятные причины конца света
МОСКВА, 05 фев — РИА Новости. Исследователи Института будущего человечества при философском факультете Оксфордского университета в Великобритании опубликовали доклад, где перечисляются основные, по их мнению, события, которые потенциально могут привести...
Найден способ определить рак легких по составу выдыхаемого воздуха
Диагностическая медицина и профилактика является, пожалуй, одним из самых важных направлений. Ведь любое заболевание гораздо лучше поддается терапии, если его выявить на ранних стадиях. Особенно это касается такой страшной патологии, как рак. Но есть одна проблема: как правило, опухолевые процессы у...
Огонь, вода, воздух, земля: самые опасные для жизни места на Земле
Многих из нас погода заставала врасплох, будь то внезапный ливень по пути домой или на работу или палящее солнце в отсутствие пляжа или какого-либо укрытия. Но это все можно пережить. Есть на нашей планете места, где матушка-природа воистину убивает. Смертельные бури, вулканические извержения &mdash...
СМИ: ученые создали самонаводящихся убийц опухолей мозга
МОСКВА, 04 фев — РИА Новости. Американские исследователи из Университета штата Северная Каролина разработали клетки, способные целенаправленно перемещаться в тканях мозга и уничтожать опухоли, пишет журнал Science Translation Medicine....
Что мы знаем о скрывающихся доисторических монстрах?
Уже больше ста лет истории об озерном монстре под названием «Мокеле-мбембе» волнуют исследователей глубоких лесов Африки. Что они нашли с тех пор? В 1981 году сообщения о живущем в озере монстре привлекли внимание Германа Регастерса, аэрокосмического инженера из Лаборатории реактивного д...
Ученые: антибиотики-"домушники" помогут победить супербактерий
МОСКВА, 3 фев – РИА Новости. Бактерии, стойкие к действию антибиотиков, можно победить при помощи массированных доз веществ, способных "продавить" систему химической защиты микроба и разорвать его оболочку, говорится в статье, опубликованной в журнале Sc...